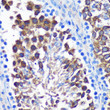
Immunohistochemistry analysis of SENP1 in paraffin-embedded Mouse testis using SENP1 Rabbit polyclonal antibody (STJ115053) at dilution of 1:100 (40x lens). Perform microwave antigen retrieval with 10 mM PBS buffer pH 7. 2 before commencing with immunohistochemistry staining protocol.

Anti-SENP1 antibody (220-420) (STJ115053)
SPECIFICATIONS
ClonalityPolyclonal
HostRabbit
ConjugationUnconjugated
IsotypeIgG
General Information
| Short Description | Rabbit polyclonal SENP1 (220-420) antibody for use in WB, IHC-P and ELISA in human, mouse and rat samples. Datasheet included with dilution recommendations, and related reagents. |
| Applications | WB/IHC-P/ELISA |
| Host | Rabbit |
| Reactivity | Human/Mouse/Rat |
| Note | STRICTLY FOR FURTHER SCIENTIFIC RESEARCH USE ONLY (RUO). MUST NOT TO BE USED IN DIAGNOSTIC OR THERAPEUTIC APPLICATIONS. |
Product Properties
| Clonality | Polyclonal |
| Isotype | IgG |
| Conjugation | Unconjugated |
| Concentration | Lot specific |
| Purification | Affinity purification |
| Dilution Range | WB:1:500-1:2000IHC-P:1:50-1:200ELISA:Recommended starting concentration is 1 Mu g/mL. Please optimize the concentration based on your specific assay requirements. |
| Formulation | PBS with 0.01% Thimerosal, 50% Glycerol, pH 7.3. |
| Storage Instruction | Store at-20°C for up to 1 year from the date of receipt, and avoid repeat freeze-thaw cycles. |
Target Information
| Gene Symbol | SENP1 |
| Gene ID | 29843 |
| Uniprot ID | SENP1_HUMAN |
| Immunogen Region | 220-420 |
| Immunogen Sequence | SRCLSSSKNTLKDSLFKNGN SCASQIIGSDTSSSGSASIL TNQEQLSHSVYSLSSYTPDV AFGSKDSGTLHHPHHHHSVP HQPDNLAASNTQSEGSDSVI LLKVKDSQTPTPSSTFFQAE LWIKELTSVYDSRARERLRQ IEEQKALALQLQNQRLQERE HSVHDSVELHLRVPLEKEIP VTVVQETQKKGHKLTDSEDE F |
| Specificity | Recombinant fusion protein containing a sequence corresponding to amino acids 220-420 of human SENP1 (NP_001254523.1). |
Additional Info
| Tissue Specificity | Highly expressed in testis. Expressed at lower levels in thymus, pancreas, spleen, liver, ovary and small intestine. |
| Function | Protease that catalyzes two essential functions in the SUMO pathway. The first is the hydrolysis of an alpha-linked peptide bond at the C-terminal end of the small ubiquitin-like modifier (SUMO) propeptides, SUMO1, SUMO2 and SUMO3 leading to the mature form of the proteins. The second is the deconjugation of SUMO1, SUMO2 and SUMO3 from targeted proteins, by cleaving an epsilon-linked peptide bond between the C-terminal glycine of the mature SUMO and the lysine epsilon-amino group of the target protein. Deconjugates SUMO1 from HIPK2. Deconjugates SUMO1 from HDAC1 and BHLHE40/DEC1, which decreases its transcriptional repression activity. Deconjugates SUMO1 from CLOCK, which decreases its transcriptional activation activity. Deconjugates SUMO2 from MTA1. Inhibits N(6)-methyladenosine (m6A) RNA methylation by mediating SUMO1 deconjugation from METTL3 and ALKBH5: METTL3 inhibits the m6A RNA methyltransferase activity, while ALKBH5 desumoylation promotes m6A demethylation. Desumoylates CCAR2 which decreases its interaction with SIRT1. Deconjugates SUMO1 from GPS2. |
| Protein Name | Sentrin-Specific Protease 1Sentrin/Sumo-Specific Protease Senp1 |
| Database Links | Reactome: R-HSA-3065679Reactome: R-HSA-9035034 |
| Cellular Localisation | NucleusCytoplasmShuttles Between Cytoplasm And Nucleus |
| Alternative Antibody Names | Anti-Sentrin-Specific Protease 1 antibodyAnti-Sentrin/Sumo-Specific Protease Senp1 antibodyAnti-SENP1 antibody |
Information sourced from Uniprot.org